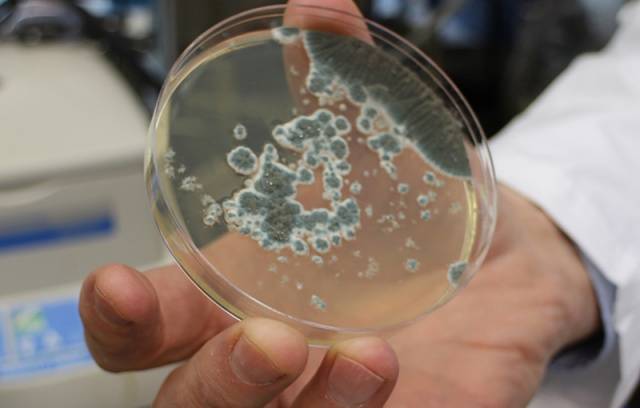

Tartalom
Egy erős és nagyméretű csaj nemcsak a fertőzésekkel szemben nagyon sérülékeny. Bármely fiatal állat fogékony a fertőzésekre a még kialakulatlan immunitás miatt. De a kislibák nagyon érzékenyek a helytelen étrendre és a testmozgás hiányára is.
Nagyon fiatalon érkeznek egy libatenyésztő gazdaság új tulajdonosához, a kislibák magukkal hozhatnak olyan fertőző betegségeket, amelyeket inkubátorban kaptak meg, vagy lúdanyától kaptak.
A kislibák betegségei, amelyekkel a csibék új tulajdonoshoz kerülnek, megfoszthatják a boldog vásárlót az újonnan megszerzett állomány 70% -ától. És néha az összes kisliba meghal.
A fiatal állatok olyan betegségei, amelyeket a kislibák magukkal hozhatnak az inkubátorból, a következők:
- szalmonellózis, más néven paratifusz:
- vírusos enteritis, gyakran a szalmonellózis következménye;
- pullorosis;
- colibacillosis, más néven colisepticemia;
- pasztellellózis.
A vírusos betegség és a betegség szövődménye által okozott enteritis általában a születés utáni 5. naptól kezdve nyilvánul meg. Az "inkubációs" enteritis jeleinek maximális időtartama legfeljebb 3 hét lehet.
A kislibák belei később gyulladhatnak, de ez már az új tulajdonosnál való tartás következménye lesz, és nem egy inkubátorból hozott betegség következménye.
Colibacillosis
A betegségnek annyi neve van, hogy a tapasztalatlan tulajdonosok könnyen összezavarodhatnak bennük. A kolibacillózist coli fertőzésnek, colidiarrheanak, colisepsisnek, madarak coliseptimizációjának is nevezik. Nyugaton egy másik név gyakori: Escherichiosis.
A betegség kórokozója az Enterobacteriaceae családba tartozó Escherichia coli baktérium különféle patogén fajai. A baktérium akár 4 hónapig is fennmaradhat a külső környezetben, de érzékeny a fertőtlenítő oldatokra.
A betegség kórokozója a beteg madarak ürülékén, felszerelésén, táplálékán, vízén és más hasonló módon terjed. A hosszú ideig gyógyult madarak továbbra is a betegség forrását jelentik, ezért maga a meggyógyult libából származó petesejt is megfertőződhet. A kikelt csaj közvetlenül az inkubátorban fertőződik meg a colibacillózissal.
Madaraknál, beleértve a kislibákat is, a colibacillosis septicemia formájában jelentkezik (a "vérmérgezés" tünetei, amelyek befolyásolják a belső szerveket: légzsákokat, tüdőt, májat, a szív külső héját és az ízületeket). Akut gyulladás alakul ki az ízületekben - ízületi gyulladás. A fájdalom miatt a madarak lábra ülnek, és nem hajlandók járni. A tüdőbetegség miatti levegőhiány következtében a kislibák korlátozzák mozgásukat - álmosság jeleivel "lefekszenek pihenni". Ez valójában a levegőhiány jele.
A szeptikémiával járó bélgyulladást (bélgyulladás) nem mindig figyelik meg. De a gyomor-bél traktus gyulladásának kialakulása esetén a kislibáknál hasmenés figyelhető meg. Néha vérrel.
A colibacillosis akut lefolyása során a madarak akár 30% -a elpusztul. A túlélő kislibáknál termelékenységük és immunitásuk kialakításának képessége tovább csökken a fertőzések elleni oltás során.
A betegség kezelése
A madarak számos más fertőző betegségétől eltérően, amelyeknél a fejsze minden betegségre nézve erősen ajánlott csodaszerként, a kolibacillózist kezelik.
A kislibák kolibacillózisát meg kell különböztetni a rossz minőségű takarmányok által okozott szalmonellózistól, pullorosistól, paszteurellózistól és enteritistől.
A betegség kórokozójának izolálását laboratóriumi körülmények között végzik, de mivel lehetetlen ennyi időt (egy hétig várni a vetésre) várni, a kezelés a betegség első jeleitől kezdődik.
Kislibáknál az étrendet úgy ellenőrzik, hogy a madarakat olyan étrendre helyezik, amely megakadályozza az enteritis kialakulását. A kezeléshez széles hatásspektrumú antibiotikumokat és antibakteriális gyógyszereket használnak: szulfonamidokat és nitrofuránokat.
Ha a kislibák állománya túl nagy és mindenkit túlhalásznak, akkor a gyógyszerek személyes terjesztésére nem lesz lehetőség, aeroszol formájában antibiotikumokat használnak a levegőben.
A betegség fő kezelésével párhuzamosan tüneti kezelést alkalmaznak, amelynek célja a madarak gyomor-bél traktusának fenntartása, valamint a kiszáradás és a mérgezés megelőzése.
Betegségmegelőzés
Madarak esetében a betegség fő megelőzése: a szoba és az inkubátor alapos fertőtlenítése formaldehid gőzökkel. Ezek az ellenőrzési intézkedések csak az óvodákra vonatkoznak.
Oldalsó kislibák vásárlásakor nem szabad őket összekeverni az állomány többi részével, amíg a csibék fel nem nőnek, és immunitásuk kialakul.
Szalmonellózis
A betegség nemcsak a madarakat, hanem az emlősöket is érinti. De a szalmonellózist a szalmonella különböző típusai okozzák. A szalmonella sokáig fennáll a külső környezetben. Fertőtlenítőszerek használata nélkül nem lehet biztos a betegség kórokozójának megsemmisítésében. Ezért, ha tavaly a gazdaságban a kislibák szalmonellózis miatt haltak meg, akkor jobb egy évet várni, mielőtt új madarakat vásárolna.
Leginkább a fiatal kislibák vannak betegek, a kifejlett libák jobban ellenállnak a betegségnek. Pontosabban, szalmonellózisuk tünetmentes. Ebben az esetben a liba már fertőzött petéket is hordozhat.
20 napnál fiatalabb kislibáknál, akiknek a betegség akut lefolyású, a szalmonellózist láz, toxikózis és bélkárosodás (enteritis) jellemzi. A betegség krónikus lefolyása során tüdőkárosodás és ízületi betegségek figyelhetők meg.
A betegség tünetei
A betegség látens periódusa 1-3 napig tart. Madaraknál a szalmonellózis akut, szubakut és krónikus. A betegség akut lefolyása során a 20 napnál fiatalabb kislibák elveszítik étvágyukat és mozgásvágyukat, vérszegénységet, hasmenést és gennyes kötőhártya-gyulladást észlelnek. Ideges rohamok jelennek meg, görcsökben kifejezve, amelyek során a kislibák kaotikus mozdulatokat hajtanak végre a fejükön, a hátukra esnek és végtagjaikat megmozgatják. A halálozás a betegség akut formájában elérheti a 70% -ot.
A betegség szubakut lefolyása az idősebb kislibáknál figyelhető meg. A betegség szubakut lefolyásának jelei a gennyes kötőhártya-gyulladás, az orrfolyás, a hasmenés, az ízületek gyulladása. Az ízületek gyulladása miatt a kislibák talpra esnek.
A legkönnyebben a kislibák tolerálják a betegség krónikus formáját, amelyet 2 hónapos korukban szenvednek. A betegség krónikus formáját hasmenés és a fejlődés késése jellemzi.
A betegség kezelése
A betegség kezelésére az antibiotikumokat antibakteriális gyógyszerekkel kombinálva alkalmazzák, a gyógyszerekhez mellékelt vagy a felügyelő állatorvos által kiadott utasításoknak megfelelően. A betegség gyógyszeres kezelésén túl a kislibák tüneti támogatását vitaminok és gyógyszerek hozzáadásával végzik, amelyek növelik a takarmány immunitását.
Betegségmegelőzés
A baromfi esetében a betegség fő megelőző intézkedése a libák tartási helyeinek és területeinek alapos fertőtlenítése, valamint új állatok vásárlása csak szalmonellózistól mentes gazdaságoktól.
Ha megkapja, vakcinázhatja a libákat élő rekombináns Salmonella vakcinával a külföldön használt madarak számára.
Pasteurellosis
Kórokozó baktérium által okozott betegség. A különböző szerotípusú pasztellellák tulajdonságai nagymértékben változnak, és nagyban függnek attól az állatfajtól, amelytől izolálták őket.
A külső környezetben a Pasteurella több naptól 4 hónapig tarthat. A határidő az állati tetemekre vonatkozik.
A paszteurella átvitelének fő módjai a légzőrendszeren és a gyomor-bél traktuson keresztül. A fertőzés egy beteg és beteg madárral, étellel, rágcsálókkal való érintkezés útján következik be. A pasztellellózisban szenvedő liba fertőzött petesejteket hordoz, amelyekben az embriók az inkubáció 9. és 15. napján elpusztulnak. Ha az embrió túlél, a kikelt gosling vírushordozóvá válik.
A betegség tünetei
A betegség inkubációs ideje 2–4 nap. Madaraknál a betegség nagyon nehéz, általános vérmérgezés jelei vannak. A madarak betegségének lefolyása hiperakut, akut és krónikus lehet.
A betegség hiperakut lefolyása a madár hirtelen pusztulásában fejeződik ki, és leggyakrabban a tulajdonosnak csak vállat kell vonogatnia. A legfeljebb 3 napig tartó és megfigyelt betegség akut lefolyása során a következő tünetek fordulnak elő leggyakrabban:
- leengedett szárnyak;
- kimerültség;
- szomjúság;
- hőmérséklet 44 ° C;
- hab a csőrből és az orrból;
- hasmenés;
- halál 18 - 72 óra alatt.
A betegség krónikus lefolyása során csak rhinitis, viszkózus váladék figyelhető meg az orrból és a szemből.
A betegség kezelése és megelőzése
A madarakat nem kezelik. Ha korábban a gazdaságban paszteurellózist regisztráltak, a madarakat az utasításoknak megfelelően beoltják a pasztellellózis ellen. Különös figyelmet fordítanak az állat- és baromfitartásra vonatkozó egészségügyi és állat-egészségügyi szabályok betartására, valamint a helyiségek és területek rendszeres fertőtlenítésére.
Pullorosis
Bakteriális betegség, amely különösen fogékony a fiatal madarakra. A kislibáknál az általános vérmérgezés és a gyomor-bél traktus gyulladásának jelei, vagyis az enteritis.
A kórokozó a Salmonella családból származó baktérium. A talajban több mint egy évig, szárított formában 7 évig tárolható. Érzékeny a fertőtlenítőszerekre.
A betegség tünetei
Veleszületett pullorosis esetén, vagyis amikor a kullancsok fertőzött petékből kelnek ki, a betegség inkubációs ideje 3-10 nap. Az ilyen kislibák általános gyengeséggel rendelkeznek, elutasítják az etetést, a sárgáját nem húzzák be teljesen a hasüregbe, és fehér folyékony ürülékük van. A kloáka körüli szöszöket ürülékkel ragasztják össze.
Beteg fiókákkal való együtt tartás következtében a kikelés utáni fertőzés esetén a betegség inkubációs ideje 2 - 5 nap. A postnatalis pullorosis lehet akut, szubakut és krónikus.
A betegség akut lefolyása során általános gyengeség, zavart emésztés, nyálkahártya fehér hasmenés és légzésre nyitott csőr figyelhető meg.
A betegség szubakut és krónikus lefolyása a kislány életének 15. napjától figyelhető meg: fejlődési késedelem, bélzavar, a lábak ízületeinek gyulladása. A betegség utolsó két típusának halálozási aránya alacsony.
A betegség kezelése
Csak a feltételesen egészséges madarakat kezelik a terramicin csoport antibiotikumával és szupportív terápiával. A beteg madarat elpusztítják.
A pullorosis megelőző intézkedései a petesejtek inkubálásával és a fiatal állatok nevelésével kapcsolatos állat-egészségügyi szabályok betartása.
Liba vírusos enteritis
DNS vírus okozza. A felnőtt libák immunisak a vírussal szemben, csak a kislibák érintettek.
A betegség tünetei
Az inkubációs periódus 2-6 napig tart.A betegség lefolyása akut. A betegség 2 naptól 2 hétig tarthat. A kislibák 60-100% -a elpusztul. A betegség jelei: gyengeség, szomjúság, étvágytalanság, nátha, kötőhártya-gyulladás, hasmenés, folyadékfelhalmozódás a hasüregben.
A hidegrázást 10 naposnál fiatalabb kislibáknál észlelik. Összebújnak, próbálnak meleget tartani. Az idősebb kislibák nem reagálnak az ingerekre és leengedik szárnyaikat, összeszedik egymást, elmaradnak a növekedéstől. 7 hetes korban az enteritis lefolyása krónikus. A kislibák legfeljebb 3% -a hal meg, a növekedés teljesen leáll.
Kezelés és megelőzés
A betegség klasszikus kezelési rendje megköveteli a lábadozó libák szérumának jelenlétét. Ma az enteritis kezelésére, és valójában a test megsegítésére, mivel a vírusok nem kezelhetők, hiperimmun szérumokat használnak, amelyek stimulálják a kislibák természetes immunitását. Az antibiotikumokat a másodlagos fertőzés elnyomására használják.
Megelőző intézkedéseket alkalmaznak a libák vírusos bélgyulladásának leküzdésére vonatkozó utasítások szerint.
Aspergillosis
Az aspergillus penész okozta betegség. Úgy néz ki, mint egy fekete virágzás a falakon és a háztartási cikkeken. Mindenhol jelen van. Nem okoz problémát a jó immunitással. Az immunitás gyengülésével a gomba szaporodni kezd a légzőszervekben.
A betegség a legyengült immunitású öreg madarakat és a fiatal állatokat érinti, amelyekben az immunitás még nem alakult ki.
Aspergillosis madaraknál
Az aspergillosis kialakulásának oka az, hogy a kislibákat nedves, sötét helyiségben tartják, és penészes gabonával táplálják őket. A gomba spórái a tüdőbe jutva csírázni kezdenek, ami a betegséget okozza.
A betegség tünetei
A penész megnehezíti a légzést, ezért a kislibák megpróbálják felköhögni a zavaró tárgyat. Légzési nehézség, nyitott csőrrel. A madár megpróbálja "belökni" egy darabját, és kinyújtja a nyakát. A penész más belső szervekké nő, hasmenést, görcsrohamokat és kötőhártya-gyulladásokat okozva.
Az aspergillosisra nincs gyógymód. A beteg madarat levágják, a helyiséget megszabadítják az állatoktól, és gondosan penészgátló készítményekkel kezelik.
Helminthiasis
A libák férgekkel fertőződnek meg, ha a víztestek közelében lévő lárvákat lenyelik.
Amidostomatosis
A libákat ezzel a fonálféreggel úgy fertőzik meg, hogy a lárvákat közvetlenül lenyelik fűvel vagy vízzel.
A betegség tünetei
A kislibák különösen érzékenyek a parazitákra. Fonálférgével megfertőzve a kullancs inaktívvá válik, gyakran a mancsukra ül, és rossz tollnövekedés figyelhető meg. A gosling elmarad a fejlődésben. Vegyes invázió esetén a kislibák gyakran meghalnak.
Hymenolipedosis
A betegség kórokozója a cestodák egyik típusa. A libák plankton vagy kagyló lenyelésével fertőződnek meg. Cestodával fertőzve kimerültség, elakadás, bizonytalan járás, görcsök, néha a végtagok bénulása és ennek következtében elesik. Folyékony alom kellemetlen szaggal.
A helmintákkal kapcsolatos betegségek megelőzése az egész állat rendszeres féregtelenítéséből áll.
A fiatal kislibák betegségei nem korlátozódnak a fertőző betegségekre. Gyakran a kislibák nem fertőző betegségekben halnak meg, amelyek elkerülhetők lettek volna a csibék helyes tartásával és étrendjük megfelelő összetételével.
Az újonnan kikelt kislibák tulajdonosai gyakran két problémával szembesülnek: a kannibalizmussal és a kislibák halálával, amikor a libával járatják őket.
Emberevés
Az állati fehérje vagy nyomelemek hiányának változata a kislibák étrendjében a kannibalizmus oka.De amikor a kislibák még nagyon fiatalok, ez a tényező valószínűleg nem számít igazán. A kannibalizmust a túl zsúfolt tartású madarak által okozott stressz is okozhatja.A tapasztalt libatenyésztőknek van más magyarázatuk.
Az élet első napjától kezdve a kullancsnak járnia kell, és meg kell rágnia a füvet. Brooderben egyszerűen nincs mit tennie, és a kislibák addig kezdik pengetni egymást, amíg meg nem véreznek. A libatenyésztők nagyon érdekes módon küzdenek a kannibalizmus megnyilvánulásaival, a videó bemutatja.
A második probléma a kislibák halála a tóban való tartózkodás után. Itt az a tény, hogy az első napokban kevés zsír van a pletyka alján. Illetve egyáltalán nincs zsír. Hosszú vízben tartózkodás után a pihe nedves lesz, a csaj pedig hipotermiában meghal.
Rickets probléma
A kislibák nagyon gyorsan növekvő madarak. 4 hónaposan már kis mértékben különböznek a szüleiktől. A gyors növekedés érdekében a kislibáknak nemcsak kiváló minőségű takarmányra van szükségük, hanem hosszú távú friss levegőn járásra is. Megpróbálva megvédeni a csibéket a betegségektől, a tulajdonosok gyakran bent tartják a madarakat járás nélkül.
Ilyen körülmények között a kislibák hajlítani kezdik a mancsaikat. Mivel a kislibák nem tudnak mozgó lábakon járni, talpra esnek. Ezt a helyzetet el lehet kerülni, ha már a korai életkortól kezdve a fiókákat hosszú sétákkal látják el, aktív mozgás lehetőségével. Ugyanakkor egy ilyen séta fű jelenlétében megoldja a libák kannibalizmusának problémáját.
A ricsa nem az egyetlen fejlődési probléma, amely a kislibákban rejtőzik. A videó egy példát mutat a szárnyakra, amelyek külső tényezők hatására hajlani kezdtek, és időben megoldották a problémát.
Következtetés
Nem szabad megfeledkezni arról, hogy a mancsokra esés önmagában nem betegség. Ez néhány súlyosabb betegség tünete. Szoros vizsgálat alapján a tulajdonos minden bizonnyal észreveszi a betegség egyéb jeleit a kislibában.